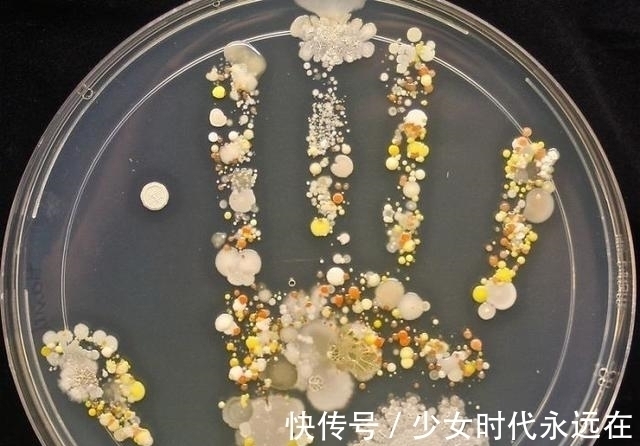
照片$30张“活久未见”的照片:被闪电击中的木头,好像一副国画

照片$30张“活久未见”的照片:被闪电击中的木头,好像一副国画( 二 )
文章插图
废弃的船已经变成流动的陆地
为什么飞机的螺旋桨拍出的照片是这样的

文章插图
好像一个微缩景观

文章插图
一个发光棒,长曝光的效果

文章插图
闪电击中沥青后的效果
好像是空中楼阁,其实是房子贴着镜子
【 照片$30张“活久未见”的照片:被闪电击中的木头,好像一副国画】
文章插图
据说这是南极,零下70度

文章插图
微波荧光棒,好奇怎么拍出来的

文章插图
一个椰子被打磨抛光后

文章插图
一辆汽车开到了不该去的地方,突然变成了艺术品

文章插图
看完后,有谁对那个椰子感兴趣的,是不是想要一个。
- 美丽家园@落叶课堂后,居然涌现那么多蓝媒“艺术家”
- 杨晓通&“当代女马可·波罗”意大利文讲述侨乡浙江瑞安非遗
- 袁侃@当石库门遇上当代艺术,来今潮8弄体验一场“城市奇遇”
- 赛事!日照“太阳城”网球公开赛启动仪式圆满举行
- 感觉|?品黄香九画“猪”
- 西装|《不会恋爱的我们》来袭,金晨化身霸总,恋上“小狼狗”王子异
- |虎年喜相“豫”!河南博物院携“青玉虎形佩”首次参与“集五福”
- 纸杯#美术生在杯子上画“知否”,当倒入水瞬间,网友:居老师挺住!
- 希腊人$古希腊眼里的中国,犹如“神族”一般,中国人看了都难以置信
- 错换人生&谁家子弟谁家院,“错换人生”DNA再掀波澜
